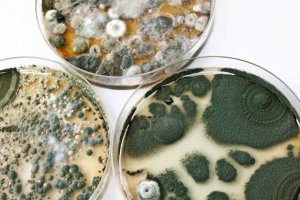
Zdroj: Grebcha – stock.adobe.com

S plísněmi bojujeme dvěma způsoby: stavebním a chemickou cestou. U prvního z nich preventivně bráníme vzniku optimálních podmínek klíčení plísní, zvláště teplotou zdiva a omezením přístupu teplého a vlhkého vzduchu. U chemické cesty povrch ošetříme sloučeninou, bránící růstu plísní.
Tvorba plísní patří ke starším zděným stavbám a mírnému klimatickému pásmu s kontinentálním střídáním teplot. Příčinou růstu plísní je vždy stav vzduchu, který neodpovídá teplotě zdiva, a přítomnost spor. Zjednodušeně teplý a vlhčí vzduch přijde do kontaktu s chladnějším zdivem. Plíseň se generuje ze všudypřítomných spor. Spory se šíří vzduchem, a po delší dobu od vzniku jsou schopny vyklíčit za příhodných podmínek. Praxe nás učí, že není nezbytně nutné překročit rosný bod, kondenzace vlhkosti není podmínkou vzniku plísní. V nevětraných dutinách bez pohybu vzduchu mohou plísně klíčit při vlhkostech již nad 60 % r. v. Tehdy je ale třeba relativně dlouhé doby (až tři měsíce) a vysoké teploty (přes 25 °C). Pokud ale vlhkost vzduchu při stěně vzroste nad 75 % r. v., zkracuje se doba na několik dnů a plísně klíčí i při teplotách kolem 20 °C.
Boj s plísněmi lze vést, a to dvěma způsoby: stavebním, kdy preventivně bráníme vzniku optimálních podmínek klíčení plísní, zvláště teplotou zdiva a omezením přístupu teplého a vlhkého vzduchu, a chemickou cestou, kdy povrch ošetříme sloučeninou, bránící růstu plísní. Chemická cesta má své úskalí – co škodí plísni, škodí, až na výjimky, také člověku nebo domácím zvířatům, případně rostlinám a dalším užitečným organismům. Vědci se po desítky let snaží najít řešení, které by selektivně zbavilo stavby plísní, a neškodilo užitečným organismům.
Jednou z těchto cest je použití stříbra jako fungicidu. Jak stříbro funguje? V první řadě, jsou to stříbrné ionty Ag+, které mají fungicidní vlastnosti. Tyto vlastnosti mají již ve velmi nízkých koncentracích, ppb (jeden díl na bilion dílů).

Mechanismus, jak stříbro likviduje bakteriální napadení, je popsán takto: Stříbrné ionty jsou schopny perforovat selektivně bakteriální buněčnou stěnu, protože reagují s peptidoglykanovou součástí stěny. Vstupují touto cestou dovnitř buňky a brání dýchání buňky. Dále modifikují metabolické řetězce, čímž buňce berou přísun živin. Třetím mechanismem je interakce s bakteriální DNA a omezení buněčné reprodukce. Velmi podobně omezuje stříbro i růst a reprodukci buněk plísní, tedy nižších hub.
Problémem výrobců protiplísňových prostředků je, jak dostat stříbrné ionty do materiálu (v našem případě nátěrové hmoty) tak, aby se z nátěru předčasně nevyplavily, nezreagovaly s chemikáliemi ze zdiva a ze vzduchu, a nepoškodily další, člověku užitečné organismy – například užitečné bakteriální kultury. Od přelomu milénia se objevují nátěry na třech principech přítomnosti stříbra:
Nátěry s nanostříbrem
Okouzlení nanotechnikou se projevilo i v průmyslu nátěrových hmot. Lze připravit kovové stříbro ve formě nanočástic kovu a jejich obrovské množství rozptýlit v kapalném médiu. Z částic se reakcí se slabě kyselým prostředím vyplavují stříbrné ionty Ag+. Hmoty s nanostříbrem se jevily jako výtečné řešení, jejich účinnost byla vysoká. Problém se projevil záhy, po několika letech. Udržet nanočástice při výrobě hmot pouze tam, kde je potřebujeme, a nekontaminovat jimi nádoby, výrobní linky a prostory se ukázalo velmi obtížným. Nanočástice stříbra končily v prostředí kolem výroben, skladů, v odpadních vodách. Jelikož stříbro dokonale likviduje bakterie, zastavilo nanostříbro činnost čistíren odpadních vod (kontaminací zařízení a obsahem v odpadu), a dostalo se do potravních řetězců v čisté vodě. Zjednodušeně – zbavením se bakterií jsme zbavili vodní toky života.
Nátěry s obsahem stříbrných sloučenin
Rozpustné sloučeniny stříbra lze ve vodě vysrážet. Jednoduchou reakcí s chloridovými ionty vzniká sraženina, nerozpustný chlorid stříbrný. Tím lze zabránit kontaminaci ionty stříbra. Jelikož nikde v záloze není téměř nekončící množství kovových částic stříbra, po jednom vysrážení již další antibakteriální aktivita nehrozí. V průmyslu nátěrových hmot ale hraje roli i barevnost. Bohužel stříbrné vodorozpustné soli reagují chemicky i s některými složkami nátěrové hmoty a způsobují její šednutí. Problém není sice tak vážný jako u jiných kovů, například železa, manganu a mědi, nevznikají barevné skvrny, ale v některých případech není možné dosáhnout zářivě bílé a jasných paletových odstínů, barvy jsou šedší.
Problémem jsou některá pojiva a levnější bílé pigmenty, reagující se stříbrnými ionty již při výrobě, nebo tónování barev. Pro tento efekt je třeba vždy barvy se stříbrem nejprve odzkoušet co do kolorovatelnosti, než se provede dotónování celého množství nátěrové hmoty.
Nátěry s mikrostříbrem
Třetí cestou, jak dopravit stříbrné ionty na „místo určení“ a nekontaminovat celou výrobní a dopravní cestu, je použití velkých částic. Z pohledu nátěrové techniky je to mikroskopická velikost, ale z pohledu nanotechniky se jedná o velké částice s chováním těžkých součástí. Velké částice lze zachytit filtry, nechat je sedimentovat, nejsou všudypřítomné. Z povrchu částic se vyplavují ionty stříbra, které jsou odpovědné za udržování nízké koncentrace, škodící právě plísním a bakteriím. Tuto nízkou koncentraci potřebujeme v praxi na povrchu filmu nátěrové hmoty, aby v případě jejího zvlhčení vytvořila pro mikroorganismy nepřívětivé prostředí, a zabránila jejich množení a růstu. Plíseň tedy vyklíčí, ale ihned zajde, neporoste. V případě, že se kousek filmu nátěrové hmoty dostane do čistírny odpadních vod nebo do vodního toku, ovlivní pouze své bezprostřední okolí. Počet částic bude nízký a konečný a částice se v krátké době usadí.
V nátěru stříbrné částice setrvávají nezměněny, dokud není jejich povrch spláchnut vodou. Tehdy se vylouží nízká koncentrace iontů, a povrch částice čeká na další použití. Úplné vyplavení stříbra může dle velikosti částic trvat dlouhá léta. Z ekologického hlediska je nátěr s mikrostříbrem bezpečnější než hmoty s nanostříbrem a jeho účinek dlouhodobější než u hmot se stříbrnými sloučeninami.




Použití na stavbě
Plísně, jako nižší houby, mají podobně jako vyšší houby své plodnice, ale i svá mycelia – na pohled zvenčí neviditelná. Pokud bychom pouze přetřeli povrch stavební části protiplísňovým nátěrem, uzavřeli bychom mycelia v podkladu, a pravděpodobně je pouze lokálně „odstínili“. Plíseň by v podkladu rostla dále, se všemi negativními zdravotními dopady na osoby uvnitř stavby. Plodnice by časem vyrazily kdesi na neošetřených plochách (např. kolem krajů ošetřených ploch) a opatření by zůstalo nefunkční. Po úspěšnou aplikaci protiplísňových nátěrů je třeba podklady, již zasažené plísní, nejprve ošetřit fungicidním napuštěním, tedy zlikvidovat hyfy, „podhoubí“ plísně.
K tomu slouží chemické prostředky, jejichž životnost je krátká, ekologicky se samy rozloží, ale v okamžiku aplikace jsou toxické. K nim patří prostředky chlorové, peroxidové, s IPBT, amoniovými solemi. Jejich úkolem je zajistit podklad bez plísní, a nátěr se stříbrem ochrání povrch před atakem zvenčí.
Nátěr se aplikuje běžnou cestou – válečkováním, stříkáním nebo štětkou. Jelikož částice stříbra jsou větší a jsou uzavřeny v těžkých kapkách nátěrové hmoty, nehrozí ani u stříkání nebezpečí kontaminace prostředí stříbrem. Jen je třeba zajistit ekologicky správnou aplikaci nátěru a likvidaci zbytků.


Životnost nátěru
Otázka životnosti nátěru je kladena z hlediska nutnosti opakování vrstvy v stavebně ohrožených detailech. Životnost z hlediska protiplísňového účinku záleží na počtu cyklů svlažení povrchu kondenzující vodou. Jiná životnost bude očekávána v potravinářském provozu typu pivovar, vývařovna, a jiná (řádově delší) bude v prostorách bytových domů. V bytech zpravidla dochází k přetírání spíše z estetických důvodů (poškrabání, ušpinění, změna barevného designu) než z důvodů ukončení fungicidní aktivity. V každém případě je životnost protiplísňového účinku daná léty, a i u extrémně namáhaných ploch (např. vjezd do myčky aut) nebyl pozorován úbytek protiplísňové aktivity ani po pěti letech.
Slučitelnost se sanačními a protiplísňovými omítkami
Důležitou otázkou je použitelnost protiplísňových nátěrů na povrch difúzně otevřených sanačních omítkových systémů. Protiplísňovým opatřením v obytných prostorách je zpravidla i výměna omítek za omítky s protiplísňovou, např. kondenzát regulující aktivitou. Takové omítky jsou vysoce nasákavé a vysoce difúzní („prodyšné“). Je tedy nutné zabezpečit, aby povrchová úprava byla rovněž nasákavá a difúzně otevřená. Ne každá interiérová „malba“ je tedy vhodná na tento typ omítek. Je třeba ověřit, zda difúzní odpor (hodnota SD) nátěru není vyšší než tento odpor u omítkové vrstvy pod ním. Jinak hrozí hromadění vlhkosti pod nátěrem a jeho odpadnutí. Pro omítky nasákavé (jako jsou protikondenzační, nebo protiplísňové) je určen nátěr nasákavý, pro omítky hydrofobní, „sanační“, se používá nátěr vodoodpudivý – hydrofobní.
Boj s plísněmi lze vést ekologicky tak, aby byly selektivně zasaženy plísně a škodlivé bakterie, a nikoli užitečné mikroorganismy. Je však třeba znát a dodržet všechna pravidla. Potom můžeme i za relativně nízké náklady získat kvalitní prostory pro bydlení, volný čas nebo podnikání a výrobu.
PAVEL ŠŤASTNÝ
Ing. Pavel Šťastný, CSc. (*1957)
Absolvent VŠCHT Praha, Chemie restaurování uměleckých děl. Praktické zkušenosti načerpal ve Státním ústavu památkové péče a jako projektant-specialista v SÚRPMO. Pracuje přes 20 let ve firmě Remmers jako produktový manažer v oblasti sanací vlhkého zdiva a obnovy památek. Zabývá se průzkumy a návrhy sanačních opatření u historických budov. Externě přednáší na FF UJEP (1999– 2021) a FSv ČVUT (od 2012). Spoluautor knih Odvlhčení staveb a Nátěry fasád (Grada).
Literatura:
Sim, W., Barnard, R. T., Blaskovich, M., Ziora, Z. M.: Antimicrobial silver in medicinal and consumer applications. A patent review of the past decade (2007-2017). Antibiotics 2018, 7, 93.
https://www.microban.com/antimicrobial-solutions/technologies/microban-silver-technology
https://www.colorificiomp.it/en/paint-with-silver-ions/
Heger, Monica: A Silver Coating in the Fight Against Microbes. Scienceline 2008, April 18.
https://www.remmers.com/de/bauten-boden schutz/schimmelsanierung/color-sa-plus/c/c5536







Nejnovější komentáře